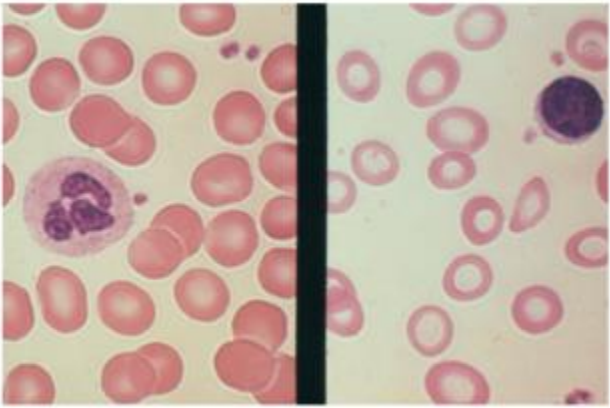
Enunciado 1570821-1

Foram encontradas 671 questões.
“O exame EAS é o exame de elementos e sedimentos anormais da urina. Em alguns locais, é também chamado de exame de Urina Tipo I. Esse exame serve para avaliar aspectos físicos (cor, pH, densidade, aspecto), químicos (presença de urobilinogênio, proteínas, nitrito, corpos cetônicos, pigmentos biliares)e a presença de elementos que normalmente não fazem parte da excreção urinária, como bactérias, cilindros, cristais, muco, hemoglobina, células epiteliais, etc.”
Disponível em: https://medicoresponde.com.br/o-que-e-o-exame-eas-de-urina-e-
para-que-serve/ .
Sobre o EAS pode-se afirmar:
Provas
“Anemia é definida pela Organização Mundial de Saúde (OMS) como a condição na qual o conteúdo de hemoglobina no sangue está abaixo do normal como resultado da carência de um ou mais nutrientes essenciais. As anemias podem ser causadas por deficiência de vários nutrientes como ferro, zinco, vitamina B12 e proteínas. Porém, a anemia causada por deficiência de ferro, denominada anemia ferropriva, é muito mais comum que as demais (estima-se que 90% das anemias sejam causadas por carência de ferro). O ferro é um nutriente essencial para a vida e atua principalmente na fabricação das células vermelhas do sangue e no transporte do oxigênio para todas as células do corpo. ”
Disponível em: http://bvsms.saude.gov.br/dicas-em-saude/431-anemia.
https://docplayer.com.br/52450257-Atlas-de-hematologia-e-analise-de-esfregacos-dosangue-periferico.html
Observando a figura acima, assinale a alternativa correta:
Provas
“O esfregaço sanguíneo bem feito é composto por três partes: espessa, medial e fina. A coloração é efetuada com corantes que tem em sua composição o azul de metileno, a eosina e o metanol. Há vários tipos de métodos: Leishman, Giemsa, May-Grunwald, Wright, panótico, etc. Alguns desses métodos necessitam de tampão com pH 7.0 e de baixa molaridade (água tamponada). A melhor análise se consegue na porção média do esfregaço, enquanto que na porção fina os eritrócitos e leucócitos aparecem geralmente com deformações artefatuais. Ao percorrer o esfregaço é necessário obedecer um padrão de deslizamento transversal e longitudinal, contemplando o corpo do esfregaço. ”
Disponível em: http://www.ciencianews.com.br/https://arquivos.infra-questoes.grancursosonline.com.br/arquivos/ACET/IMAGENS/Artigos_cientifi
cos/Interphemo.pdf.

figura disponível em: https://docplayer.com.br/52450257-Atlas-de-hematologia-e-analise-de-esfregacos-do-sangue-periferico.html
Observe o esfregaço sanguíneo e marque a alternativa correta:
Provas
“A farmacotécnica é a área de responsabilidade dos farmacêuticos, que tem compreende a manipulação dos princípios ativos e outras substâncias necessárias para a fabricação de medicamentos. A seleção da forma farmacêutica ideal é um parâmetro de grande relevância para a qualidade farmacotécnica de um medicamento. A manipulação de medicamentos tem como objetivos o uso racional, evitando perdas e desperdícios, o ajuste de dose, de acordo com as necessidades clínicas dos pacientes, como também promover maior facilidade na administração de medicamentos, para atender as especificidades de cada paciente. Por esses motivos, as formas farmacêuticas são selecionadas com base na via de administração requerida, bem como em critérios como estabilidade físico-química do princípio ativo, entre outros. Conceitualmente, a forma farmacêutica é a forma final em que se apresenta o medicamento ao paciente, depois de uma série de operações farmacêuticas realizadas com o princípio ativo e os excipientes adequados, ou sem os excipientes também, com o objetivo de atingir o sucesso terapêutico de acordo com a via de administração mais adequada. ”
Disponível em: https://www.editorasanar.com.br/blog/farmacia-formas-farmaceuticas-
artigo-tudo-que-voce-precisa-saber
A respeito das formas farmacêuticas e vias de administração de medicamentos, é CORRETO afirmar:
Provas
“Uma compreensão detalhada do tempo de curso da viremia e da soroconversão durante a infecção primária pelo HIV é prérequisito importante para entender e aperfeiçoar fluxogramas diagnósticos. Nesse sentido, Fiebig e colaboradores (2003) propuseram um sistema de estagiamento laboratorial da infecção recente pelo HIV-1 que inclui também projeções da duração de cada estágio, com base no padrão de reatividade de diferentes ensaios – RNA viral, antígeno p24, IE de terceira geração e Western blot. Uma primeira observação importante é a de que a reatividade dos diferentes tipos de ensaios para a detecção da infecção pelo HIV progride sequencialmente e permite que a cada aparecimento de um marcador na circulação, seja atribuído um estágio à infecção. Assim, cada um dos seis estágios é definido por um padrão único de reatividade a um ou mais ensaios. Esse sistema classifica em detalhes as fases iniciais da infecção e facilita o entendimento de qual teste ou fluxograma é mais indicado para fazer o diagnóstico da infecção pelo HIV em diferentes situações.”
Disponível em: http://bvsms.saude.gov.br/bvs/publicacoes/manual_tecnico_diagnostico_infeccao
_hiv.pdf.
Tabela 4 - Classificação de Fiebig para Estagiamento Laboratorial da Infecção pelo HIV.
Estágio | Marcador | Duração em dias (IC 95%) | ||||
RNA | p24 Ag | IE (3aG) | WB | Individual | Cumulativo | |
0 | - | - | - | - | 10 (7-21) | 10 |
I | + | - | - | - | 7 (5-10) | 17 |
II | + | + | - | - | 5 (4-4) | 22 |
III | + | + | + | - | 3 (2-5) | 25 |
IV | + | +/- | + | Ind | 6 (4-8) | 31 |
V | + | +/- | + | +(-p31c) | 70 (40-122) | 101 |
VI | + | +/- | + | +(+p31) | Sem limite de duração | Sem limite de duração |
Coben et. al J. Infect Dis. 2010, 202 (S2):s270-s277
Com base no texto e na tabela acima pode-se afirmar:
Provas
“Dos pontos de vista fisiológico e clínico, os lípides biologicamente mais relevantes são os fosfolípides, o colesterol, os Triglicérides (TG) e os ácidos graxos. Os fosfolípides formam a estrutura básica das membranas celulares. Eles circulam na corrente sanguínea ligados a proteínas específicas formando complexos denominadas lipoproteínas, sendo que estas permitem a solubilização e o transporte desses elementos. A determinação do colesterol ligado a essas lipoproteídas, chamado Lipidograma ou Perfil Lipídico, direciona o tratamento e prevenção da aterosclerose, condição ligada a problemas cardíacos. ”
Disponível em: http://www.scielo.br/scielo.php?script=sci_arttext&pid=S0066-
782X2017001100001.
Sobre essas determinações, analise as afirmativas e escolha alternativa certa.
Provas
“Quando um paciente com anemia (Hb abaixo do valor padrão) se apresenta com o VCM e HCM diminuídos, denomina-se anemia microcítica e hipocrômica; se o VCM e HCM estiverem dentro dos valores da faixa de normalidade, a anemia é normocítica e normocrômica; e se o VCM estiver elevado (não há HCM elevado!) a anemia é do tipo macrocítica.”
Disponível em:
http://www.ciencianews.com.br/https://arquivos.infra-questoes.grancursosonline.com.br/arquivos/ACET/IMAGENS/Artigos_cientificos/Inter phemo.pdf .
Consideremos os exemplos de três diferentes mulheres adultas, comparando seus resultados com os da tabela. Pode-se afirmar:
--------------------------------Caso 1 ---------------Caso 2 -------------Caso 3
Eritrócitos (x 106) ------------------3,8 -----------------3,3 -----------------2,8
Hemoglobina (g/dL ---------------8,5 -----------------9,0 -----------------8,3
Hematócrito (9%)----------------- 27 -----------------30 -----------------27
HCM (pg) ------------------------22 -----------------27 -----------------28
VCM (fL) --------------------------71 -----------------90 -----------------96
CHCM (g/dL) ---------------------31 -----------------30----------------- 30
RDW (%) --------------------------16 -----------------17 -----------------16
Provas
“A amostragem é um procedimento definido, pelo qual uma parte de uma substância, material ou produto é retirado para produzir uma amostra representativa do todo para o ensaio. O resultado obtido através da análise laboratorial é determinado em grande parte, pela primeira etapa do processo de análise que é a amostragem. Uma amostragem incorreta resultará em uma análise que não revelará a verdade sobre o produto amostrado, portanto, a amostra deve ser representativa de um todo. ”
A amostragem deve resultar em uma amostra que preserve suas características originais. Para tanto, alguns cuidados devem ser observados no momento da coleta, como:
Provas
“As plaquetas são também produzidas na medula óssea e derivam da fragmentação do citoplasma dos megacariócitos. Tem forma discóide, são anucleares e estão presentes no sangue em quantidades variáveis entre 140 e 450 x 103/mm3. Seu tempo de vida média é variável entre nove e doze dias. A atuação fisiológica das plaquetas é fundamental no processo inicial da hemostasia, promovendo a agregação dessas células e a adesividade delas com as células endoteliais próximas às lesões. Durante essas atividades hemostáticas, as plaquetas funcionam como tampões e promovem o desencadeamento da coagulação sanguínea. Por essas razões a contagem total de plaquetas e a análise da sua morfologia são muito importantes. ”
Disponível em:
http://www.ciencianews.com.br/https://arquivos.infra-questoes.grancursosonline.com.br/arquivos/ACET/IMAGENS/Artigos_cientificos/Inter
phemo.pdf.
Com relação às plaquetas pode-se afirmar:
Provas
“A análise da série branca é também conhecida por leucograma e avalia as contagens total e diferencial (valores relativo e absoluto) dos leucócitos, bem como a morfologia dos neutrófilos, linfócitos e monócitos, principalmente. ”
Disponível em:
http://www.ciencianews.com.br/https://arquivos.infra-questoes.grancursosonline.com.br/arquivos/ACET/IMAGENS/Artigos_cientificos/Inter
phemo.pdf.
A avaliação quantitativa, que incluem as contagens total e diferencial é baseada em valores padrões estabelecidos por faixas etárias conforme mostra a tabela acima, com base nisso assinale a alternativa correta:
Provas
Caderno Container